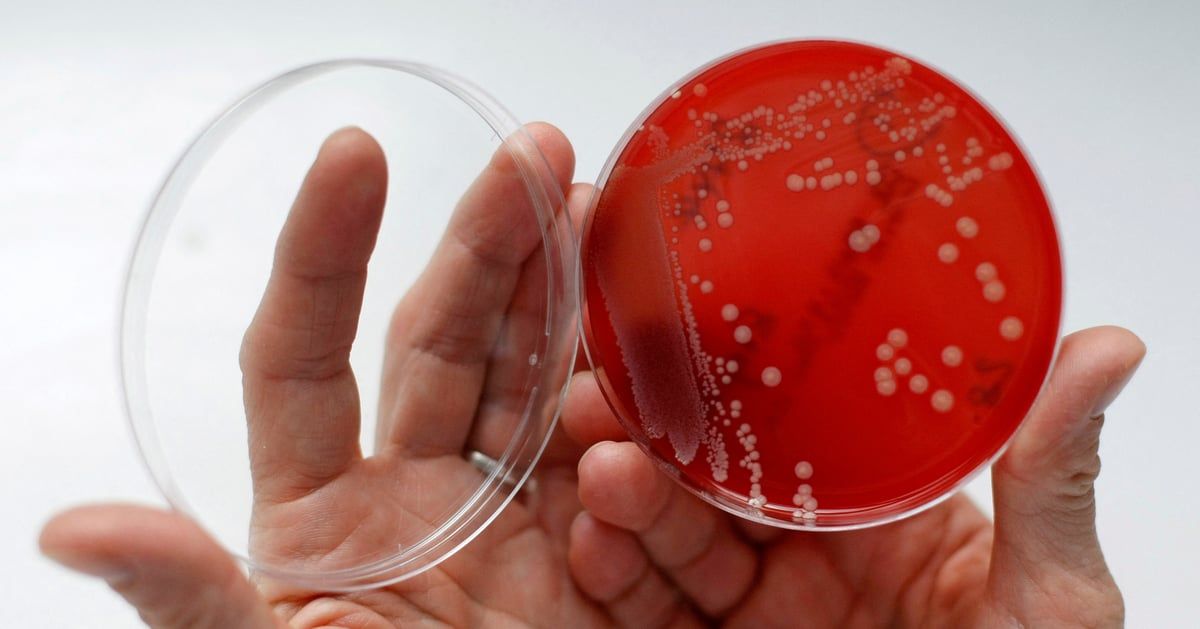
مضاد حيوي شائع يقلل وفيات "متلازمة الإيماء"

محمد الرخا - دبي - الأحد 9 يونيو 2024 07:10 مساءً - وجدت دراسة جديدة أن "الدوكسيسيكلين"؛ وهو مضاد حيوي شائع، يمكن أن يقلل بشكل كبير من حالات الوفاة المرتبطة بالنوبات الحادة بين المرضى الذين يعانون من متلازمة الإيماء.
ومتلازمة الإيماء حالة عصبية منهكة تؤثر في الغالب على الأطفال والمراهقين في شرق أفريقيا.
وبحسب تقرير نشره موقع "نيوز ميديكال"، تسبب متلازمة الإيماء إعاقات عقلية وجسدية شديدة ونوبات مهددة للحياة.
وربطت الأبحاث الحديثة هذه الحالة بعدوى "كلابية الذنب المتلوية"، وهو الطفيلي المسؤول عن داء كلابية الذنب أو العمى النهري.
ووفر هذا الإنجاز أساسًا لدراسة ما إذا كان "الدوكسيسيكلين"، المعروف بعلاج داء كلابية الذنب، مفيدًا أيضًا للمرضى الذين يعانون من متلازمة الإيماء.
وترأس الدراسة، التي مولها مجلس البحوث الطبية في المملكة المتحدة، الدكتور ريتشارد إدرو من جامعة ماكيريري في أوغندا، بالتعاون مع خبراء من كلية ليفربول للطب الاستوائي، وجامعة أكسفورد، والمعهد الوطني الأمريكي للصحة، ووزارة الصحة الأوغندية، وكلية لندن للصحة والطب الاستوائي.
واكتشف الفريق أن دورة من "الدوكسيسيكلين" تتحكم بشكل كبير في النوبات الشديدة الناجمة عن العدوى لدى مرضى متلازمة الإيماء، وتقلل من الأجسام المضادة لطفيل كلابية الذنب المتلوي.
وقال الدكتور إيدرو: "لا تؤكد هذه الدراسة الارتباط بين العدوى بدودة الفيلاريا كلابية الذنب المتلوية فحسب، بل تشير أيضًا إلى أن الوقاية من العدوى المسببة للحمى باستخدام العلاج الوقائي بالمضادات الحيوية يمكن أن تقلل بشكل كبير من حالات دخول المستشفى والوفيات الناجمة عن متلازمة الإيماء".
وسلط البروفيسور مارك تايلور، من كلية ليفربول للطب الاستوائي، وهو مؤلف ورائد في علاج "الدوكسيسيكلين" لداء كلابية الذنب، الضوء على الآثار الأوسع للنتائج.
كما توضح هذه الدراسة فائدة أخرى لاستخدام "الدوكسيسيكلين" لعلاج داء "كلابية الذنب"، عن طريق الحد من دخول المستشفى والوفيات المرتبطة بمتلازمة الإيماء.
وفي ضوء هذه النتائج الواعدة، أكد فريق البحث أهمية إتاحة الأدوية المضادة للنوبات في المجتمعات الفقيرة المتضررة من الصرع المرتبط بداء كلابية الذنب (OAE).
ودعا الفريق إلى تكثيف الجهود داخل المجتمع العلمي لتحديد الآليات الأساسية لمتلازمة "الإيماء" لتطوير أساليب علاجية جديدة.
ولا تفتح الدراسة آفاقًا جديدة لاستخدام "الدوكسيسيكلين" في علاج متلازمة الإيماء فحسب، بل تشجع أيضًا على إجراء المزيد من التحقيقات في الأسباب الدقيقة لهذه الحالة؛ ما قد يؤدي إلى تحسين الإدارة السريرية واستراتيجيات علاجية جديدة.
